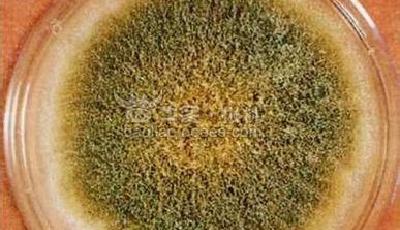
“吉祥結(jié)”花生油含強致癌黃曲霉毒素B1

感谢您访问我们的网站,您可能还对以下资源感兴趣:果洛氛醇货运代理有限公司
九九视频在线播放,九九热在线视频观看,**毛片网站,日本播放一区二区,久久久久99啪啪免费,99久久精品免费看国产四区,久久成人av电影,日韩一区二区黄色片
网站地图
亚洲成人av在线播放
欧美日韩一区二区不卡
97品白浆高清久久久久久
黄色高清av
国产欧美一区二区三区视频在线观看
亚洲视频一区二区在线
午夜一级片
国产免费av一区二区
成人黄色在线
国产精品欧美一区二区
精品久视频
亚洲日本欧美在线观看
亚洲天堂在线观看视频
久草国产精品
精品香蕉99久久久久网站
在线观看中文字幕一区二区
久久精品视频久久
国产午夜精品一区二区
催眠指导全集
久久电影精品
亚洲综合一二区
久久99久久精品
国产精品久久77777更新时间
久久久综合久久久
国产精品久久久久999
天躁狠狠躁
超碰国产天天做天天爽
99精品视频在线
日本播放一区二区
日本免费一区二区在线观看
国产高清在线精品一区
日本在线观看一区
青青青爽久久午夜综合久久午夜
成年人在线观看视频网站
黄色av一级片
日本中文一区二区
久久久国产99久久国产久灭火器
日本久久久久久久做爰图片
国产一区二区三区视频网站
未来战队时间连者
国产精品www在线观看
精品欧美一区二区久久久
久久五月天av
亚洲精品福利在线观看
国产精品欧美精品日韩精品
久操精品在线观看
av成人观看
亚洲一区二区激情
久久国产精品视频观看
亚洲国产精品自拍
国产91精品看黄网站在线观看
久久99精品久久久久久久青青日本
av亚洲免费
日本一区二区三区精品视频在线观看
欧美精品2
国产精品久久久久久久久久久久久久
国内精品久久久久久久久久清纯
日本精品免费在线观看
污污在线免费观看
国产精品性做久久久久久
国产精品xxx在线观看
久久精品视频99
97色在线观看免费视频
激情欧美在线
一级高清黄色片
国产精品不卡在线观看
无尽夜久久久久久久久久
99久久久久
37人体做爰久久久久久
国产精品wwww
日韩成人精品视频在线观看
国产免费又色又爽又黄在线观看
亚洲一区色
成人av免费观看
性高湖久久久久久久久
国产一级免费看
国产免费久久精品
久久久久久a女人
黄色一级电影免费观看
国产精品免费一区二区三区在线观看
日本视频一二三区
国内一级黄色片
在线观看一二三区
中国一级毛片免费观看
九九中文字幕
免费黄色在线播放
欧美国产日本在线观看
日本福利一区二区三区
国产一区免费观看
视频在线观看一区二区三区
99热这里只有精品在线观看
亚洲一区二区三区免费
日韩欧美不卡一区二区
在线观看成人黄av免费
免费在线观看一区二区三区
99久久精品国产一区二区成人
又色又湿又黄又爽又免费视频
成人亚洲性情网站www在线观看国产
国产激情久久
久久久久久中文
粉嫩av一区二区在线观看
国产日韩久久久
日本特黄久久
av免费在线观看一区
日韩区一区二
狼人av在线
日本一区二区免费在线观看
寡妇高潮一级寡妇房间
成人黄色亚洲
男儿当入樽粤语版全集
日本天天躁狠狠躁噜噜噜
伊人色综合久久天天五月婷
亚洲观看在线
美女被脱脱内衣免费网站
在线欧美一区二区
精品久久8x国产免费观看
一区二区成人在线观看
亚洲成人a
av黄色免费在线观看
蜜桃av一区二区
99精品国产高清一区二区麻豆
av一级在线观看
久久精品色视频
欧美精品一区二区三区免费播放
久爱www人成免费网站下载
国产综合久久久
天天操夜夜操狠狠
国产一级内谢一级一内高请
亚洲免费视频一区
国产一区91
69国产精品久久久久久
美女污污视频在线观看
手机在线观看一级片
在线观看亚洲专区
蜜臀av观看
久久久久九九九九
国产高清黄色
婷婷情更久日本久久久片
国产精品一区av
亚洲观看在线
激情久久中文字幕
婷婷综合五月天
精品无码一区在线观看
99riav精品免费视频观看
久久久久久久久一区
91视频久久久久
欧美一卡二卡在线观看
一级做a爰片久久免费观看
国产高清久久久
久久久久久久久久久电影
亚洲3p激情在线观看
国产123区在线观看
国产精久久久久久
爱插综合网
国产伦精品一区二区三区免费视频
国产精品欧美日韩
av一区二区不卡
国产视频1区2区3区
国产精品久久久久久久泡妞
国产精品99久久久久久大便
亚洲国产一区av
亚洲a在线观看视频
在线a亚洲视频播放在线观看
国产片黄色
在线观看亚洲a
久艹在线视频
亚州一区二区三区
成人黄色在线
日韩精品久久久久久久玫瑰园
国内精品久久久久久久久久久
欧美伦理电影一区二区三区
国产伦理一区二区
国产欧美精品一区二区三区
成年人视频免费在线播放
www.久久久久久
伊人成人在线观看
日韩中文字幕一二三区
大佬的365天第二季免费观看高清版全集
欧美性猛交乱大交丰满
久久综合狠狠综合久久综青草
www.av一区
久久久久夜色
国产午夜精品一区二区三区
亚洲一区观看
久久精品丝袜
高清视频一区
免费观看黄色
国产高清免费av
中文字幕二三区
一区二区三区视频在线免费观看
久久久久精彩视频
亚洲精品一区二区三区区别
一区二区视频免费看
欧美激情视频在线免费观看
久久久人人爽
亚洲一区二区网站
日本免费一区二区三区
精品久久电影网
久久久久久久免费视频
91偷拍一区二区三区精品
免费观看一区二区三区视频
久久久免费精品视频
亚洲一区二区在线免费观看
国产亚洲精品成人av久久影院
99精品久久久久久中文字幕
国产精品久久在线观看
久久久久久草
日韩av在线免费
**毛片在线观看
在线观看污污网站
欧美日一区二区
久久久av一区二区
人人爱av
99精品久久久久久中文字幕
黄污视频在线看
国产一区三区视频
国产亚洲欧美另类一区二区三区
亚洲三区视频
99久久精品国产成人一区二区
好深好湿好硬顶到了好爽免费视频
久久久久91视频
成人区一区二区三区
精品国内自产拍在线观看视频
亚洲成人av资源
国产一区二区日本
伊人网站在线观看
伊人av导航
日本黄色高清视频网站
少妇bbb搡bbbb搡bbbb′
色婷婷精品国产一区二区三区
av一区二区三区在线观看
激情一区二区三区四区
久草在线久草在线2
久久99精品国产.久久久久
欧美电影一区二区三区
诱人的美容院2
国产成人高清成人av片在线看
久久9999久久
欧美大黄视频
亚洲a一区二区
91久久久久久久久久久久久久久久
成人久久av
午夜大片一区
国产伦精品一区二区三区照片
日本一区二区三区视频在线观看
亚洲成人av在线播放
99国产精品视频免费观看
亚洲码一区二区三区
五月天婷婷色
久久精品永久免费
欧美国产激情二区三区
久久综合狠狠综合久久综合88
午夜a级片
99re国产在线观看
久久久久久久久99精品大
国产一区二区三区免费在线
亚洲一区二区三区视频
国产免费一区二区三区四在线播放
一级黄色大片在线观看
五月天堂av
全国最大成人免费视频
亚洲国产一区av
av一区二区三区在线播放
日日噜噜噜噜久久久精品毛片
久久久国产精品网站
久久久久久国产电影
久久久久久免费毛片精品
主人~别揉了~屁股~啊~嗯
亚洲国产日本
可以在线免费观看的av
久久69国产精品久久77
午夜av电影
久久激情久久
黄色av免费在线观看
无遮挡肉动漫
一级片免费在线观看视频
久久精国产
久久www免费人成网站
热re99久久精品国产99热
日本一二三区在线观看
黄色av网站免费
又黄又刺激又爽的免费播
激情久久久久久久久久
国内精品久久久久影视老司机
久久久久久影院
无码中文字幕日韩专区
蜜桃精品噜噜噜成人av
国产欧美精品aaaaa久久
在线观看中文字幕一区二区
噜噜噜久久
日韩中文字幕一二三区
性高湖久久久久久久久aaaaa
在线观看国产黄色
久久高清国产
99国产精品视频免费观看一公开
国产四区在线观看
少妇超碰在线
日韩一区二区视频在线
婷婷在线观看视频
av一级在线观看
一区观看
国产成人免费片在线观看
九九热在线观看免费视频
午夜激情影视
色噜噜狠狠一区二区三区
亚洲高清av一区二区三区
国产免费一区二区三区最新6
1000国产精品成人观看视频二
蜜桃av噜噜一区二区三区
欧美一级欧美三级在线观看
日韩大片一区二区
久久伊人影院
久久久国产三级
久久精品网站免费观看
爱插综合网
亚洲日本成人在线观看
国产一级二级三级在线观看
亚洲精品成人18久久久久
久久久久久毛片
亚洲视频一区二区三区
av色在线观看
色哟哟一一国产精品
催眠指导全集
国产精品久久久777777
日韩精品久久久久久久九岛
国产嫩草一区二区三区在线观看
av一区不卡
久久国产v
污小说视频
久久久久久久a
99久久精品免费
亚洲码一区二区三区
久久久久久久久毛片
久久国产一片免费观看
成人区一区二区
欧美国产日本在线观看
亚洲一区二区免费在线
伊人av在线免费观看
久久久久久看片
二区三区在线视频
久久久久久久久精
欧美三级不卡在线观看
污在线视频
久久久噜噜噜久久
国产精品久久久久9999高清
伊人久久久久久久久久久
午夜免费在线
夜间av免费看精品
www.成人在线观看
婷婷情更久日本久久久片
日本高清视频一区
欧美又粗又大又硬又长又爽视频
久久久久久久999
蜜桃av在线看
久久色精品
亚洲国产精品一区
国产一线二线在线观看
亚洲综合av一区二区三区
99久久综合精品五月天
久久久国产精品麻豆
日韩一区二区在线播放
在线国产精品视频
久久91视频
精品国产一区二区三区麻豆小说
欧美日韩精品一区二区
99久久久久久
www天堂在线观看
国产高清aaa
久久精品久久久久久久
蜜桃一区二区在线观看
让男生摸美女光屁屁无遮挡
国产精品久久电影观看
国产精品岛国久久久久久久久红粉
久久视频二区
av在线一区二区三区
国产高清av在线
黄色av影院
亚洲免费观看av
国产精品久久久久久久第一福利
国产精品一区二区三区四区
区一区二在线观看
久久久免费看片
婷婷成人av
精久久久久久久
一级视频在线免费观看
午夜视频免费试看
国产伦理一区二区
99精品视频99
中文字幕av三区
九九只有精品
国产精品国产三级国快看
av大全在线免费观看
亚洲天堂色播
99久久综合精品五月天
蜜桃av噜噜一区二区三区小说
久久精品5
午夜精品欧美
亚洲精品二三区
91视频久久久久
国产婷婷精品av在线
久久久久久国产精品久久
免费一级肉体全黄毛片高清
日韩在线观看一区二区
热久久久久久久久久
男狂揉女胸60分钟视频
一边摸一边吃摸大了再吃
久久久久久中文
亚洲国产精品视频在线观看
久久激情视频网
亚洲aⅴ一区二区
成年视频免费高清在线看
一区二区三区亚洲精品国
九九九九久久久久
婷婷av综合
精品国产一区二区三区日日嗨
国产精品99久久99久久久二
亚洲一区二区三区网站
欧美激情视频网站
免费黄色在线视频网站
国产一级淫片a视频免费观看
999久久a精品合区久久久
亚洲色图av在线
日韩精品中文字幕有码
免费看黄色片子
日韩亚洲色图
久久精品欧美一区二区三区麻豆
九九九九热精品免费视频点播观看
污污动漫在线看
久久99精品久久久久久6194
国产伦精品一区二区三区免.费
亚洲无人区一区二区三区入口
国产成人精品av在线
亚洲国产高清自拍
蜜桃av久久
蜜桃传媒一区二区亚洲
精品国产黄a∨片高清在线
日韩av女优一区二区
亚洲一区二区三区精品在线观看
91久久久久久
蜜桃av噜噜一区二区三区小说
999久久久免费看
美女污网站
污污动漫网站
一区二区视频免费
亚洲一区二区观看
欧美精品第一页
久久久久久久国产精品美女
精品一区二区三区在线观看
久久久受www免费人成
日韩精品一二三四区
久久精品资源
久久久激情
婷婷成人av
久久av一区二区三区亚洲
在线观看精品
国产伦精品一区二区三毛
亚洲天堂精品视频在线观看
国产污片在线观看
av日韩一区二区三区
99er在线观看
亚洲一区二区动漫
久久国产免
国内精品久久久久影院优
92精品国产成人观看免费
久久久久久久久伊人
99国产精品视频免费观看
亚洲一区二区动漫
亚洲二区在线视频
孟姜女哭长城原版
污污动漫网站
日本护士hd丰满护士
岛国精品在线播放
亚洲情一区
少妇特黄一区二区三区
亚洲天堂成人在线观看
国产精品99999
狠狠噜天天噜日日噜
可以看的免费av
久久精品免费网站
97久久精品
国产精品视频一区二区三区
美女高潮久久久
国产专区视频在线观看
欧美性猛交乱大交丰满
av在线一二三区
久久久这里有精品
久久精品国产亚洲
蜜桃av一区二区
亚洲欧美视频在线观看
在线免费观看三级电影
日本高清在线一区二区三区
97超级在线观看免费高清完整版在线观看
国产精品av在线免费观看
黄色av片在线观看
国产黄色免费观看
91国内精品久久久久
91精品久久久久久久久99绯色
亚洲综合1区
一区二区亚洲
www.久久久久久久.cnn
亚洲免费在线观看av
久久久久久久久99精品大
免费观看成年人网站
天天色综合久久
欧美日韩亚洲一区
不卡一区在线
国产成人小视频在线观看
久久加久久
精品国产乱码久久久久久绯色
97久久精品视频
久久久久久久久久性
亚洲综合av一区二区
亚洲一区你懂的
一区二区在线观看中文字幕
一本精品999爽爽久久久
久久久99精品免费观看
国产又粗又爽又深的免费视频
国产欧美在线一区二区三区
欧美精品二区三区四区免费看视频
欧美性猛交xxxx乱大交丰满
一区二区三区av
www裸玉足久久久
久久久久久久久久久综合
国产成人av一区二区三区
亚洲一区二区三区在线观看视频
国产一区日韩
日本一二三区高清
成人国产精品免费观看
色噜噜狠狠狠综合曰曰曰
思思久久精品
久草国产在线观看
我的黑帮大佬第2季免费观看高清
国产精品国产三级国产aⅴ入口
成人av在线高清
我和黑道大佬的365天
又黄又爽的视频网站
日本在线观看一区二区三区
久久97精品久久久久久久不卡
日本伦理一区二区三区
在线观看成人av
在线亚洲一区二区
免费毛片在线播放
日日夜夜狠狠干
成人精品片
美女无遮挡免费视频
99se精品视频在线观看
在线观看精品
成人精品三级av在线看
校花在校长室被调教h
一区二区三区在线免费播放
一级少妇精品久久久久久久
av高清一区二区
狼人av官网
亚洲国产高清av
国产精品第八页
久久久久久一区
全免费观看一级
日本午夜激情
高潮久久久
中文字幕在线观看国产
亚洲一区三区在线观看
一级一片免费观看
日韩av女优一区二区
日本成人综合
西宫电视剧
av一级黄色片
久久超碰在线
好硬好湿好爽再深一点h视频
亚洲国产精品一区
国产九九久久
丰满少妇白浆高潮呻吟
久久国产区
九九九久久久久
91av蜜桃
婷婷在线观看视频
一级做a爰片久久免费观看
亚洲精华液一区二区三区
亚洲自拍一区在线观看
国产99在线|欧美
色一情一乱一伦一区二区三区
日本一区二区免费在线观看
啊灬啊灬啊灬快灬高潮了在线看
精品视频久久久
国产精品久久久精品小说
国产九九久久
久久久久中文字幕亚洲精品
欧美日韩国产精品一区
国产永久免费av
亚洲无人区一区二区三区入口
国产91久久久久久
五月黄色网
国产精品一级在线观看
国产成人欧美
aaa影院
亚洲精品欧美综合网
国产精品伦一区二区
精品久久久久久久久久久国产字幕
亚洲欧洲日韩二区aaaaa
天堂av网在线
我和大佬的365第二季免费观看
美女露出奶子
精品性高朝久久久久久久
亚洲v欧洲一区二区三区
被男狂揉吃奶胸90分钟视频
久久久亚洲一区二区三区
脱美女内衣视频网站
97品白浆高清久久久久久
精品成人av一区二区三区
国产福利视频在线观看
黄色片免费在线
久草热在线观看视频
国产视频一区二区在线观看
久久91精品视频
中文字幕二三区不卡
久久综合激情
日韩国产一区
中文字幕中文字字幕码一二区
精品乱码一区二区三四区视频
黄色av免费看
国产精品久久高潮
久久久涩涩涩
欧美亚洲国产精品
亚洲一区二区三区在线视频
99久久精品国产成人一区二区
福利在线一区二区
久久91视频
蜜桃av免费在线观看
亚洲综合一区二区三区四区
精品日本久久久久久久久久
桃花村艳妇野欲
91久久精
久久蜜桃精品
高清成人综合
国产精品乱码一区二区视频
在线日韩一区二区
久久国产一片免费观看快手
中文av影院
人人艹视频
午夜精品一区二区三区在线观看
欧美精品在线免费观看
日韩区一区二
久久久久久久久免费
久久免费看毛片
99久久免费精品高清特色大片
xxxx69hd
久久久久久国产电影
一级在线免费观看视频
成人黄色精品
在线观看国产成人
一区精品视频
97久久久久
亚洲一区在线看
日本三级日本三级韩国三级视
日韩欧美精品一区
日韩大片一区二区
午夜www
日本高清一区
日韩中文字幕一区二区
免费看男女高潮又爽又猛视
亚洲日本成人
精品国产免费久久久久久桃子图片
久久久99色
一区二区不卡av
av免费影院
日韩精品91偷拍在线观看
日韩一区在线免费观看
午夜av电影
五月婷婷在线观看
成人免费视频播放
女人天堂av手机在线
夜夜高潮久久做爽久久
亚洲国产精品久久久久久久久久
久久精品视频8
久久精品视频91
中文字幕国产高清
久草在线观看福利
美女被脱脱内衣免费的软件
亚洲一区二区三区高清
国产伦精品一区二区三区在线播放
国产黄色片免费观看
久久久久久夜夜夜猛噜噜
国产伦精品一区二区三区免.费
韩国一区二区三区电影
福利一区在线视频
国产一级免费看
美女不遮不挡的免费视频裸体
国产黄色网址在线观看
久久久精品免费观看
精品久久久一区二区
91精品网
观看一级视频
国内精品久久久久久久久久久
成人av免费观看
亚洲一区二区三区精品在线
欧美精品1区2区
亚洲综合一区二区三区四区
国产激情综合五月久久
欧美一区二区三
99精品国产一区二区
国产在线观看黄色
国产精品久久久久永久免费看
亚洲一区亚洲二区
亚洲免费观看高清完整版在线
日韩一区二区在线播放
国产成人高清成人av片在线看
日韩精品一区二区在线观看
日韩av一区二区在线
日本一区免费在线观看
国产精品9999
精品少妇一区
日韩午夜影院
亚洲成人一区二区三区在线观看
国产亚洲精品资源在线26u
日本一区二区三区在线播放
日韩美女一区二区三区在线观看
国产91在线播放九色快色
免费久久久
九九精品视频在线观看
一本一道久久a久久综合蜜桃
亚洲一区二区三区伦理
五月婷视频
久久久久久久国产精品免费播放
96久久精品
成人免费看视频
精品一区二区三区视频在线观看
久久久精品视频在线观看
一区二区免费av
国产一区二区免费在线播放
久久99久久99精品免观看粉嫩
性高潮久久久久久久久
国产一区二区在线视频
欧美a级在线免费观看
免费观看一级黄色片
黄色国产免费观看
国产一区二区在线播放
少妇**挤奶水中文视频毛片
91久久久久久久久
久久久久综合狠狠综合日本高清
亚洲av毛片一区二区三区电影
久久久社区
国产精品久久免费
美日韩一二三区
一区二区三区亚洲
亚洲一区二区三
99精品视频在线观看免费
黄色av网站免费
亚洲一区二区三区色
久久69国产精品久久77
中国黄色片在线观看
a级在线观看视频
日韩精品久久久久久久白丝
久久久久97国产精
毛片一级在线观看
高h辣肉各种姿势爽文1v1娇妻
一级久久久久久久
亚洲精品久久久久中文第一幕
国内精品久久久久久久久久久
在线观看免费视频国产精品
日韩美一区二区
国产三级电影免费观看
黄色国产在线观看
日韩一区二区影院
亚洲国产电影一区二区三区
久久中国国产
污在线播放
久久九九精品
av亚洲在线观看
99精品视频在线导航
久久黄色免费观看
国产一区不卡
国产三区四区视频
午夜激情视频免费观看
懂色一区二区三区免费观看
在线看一区二区
久久嫩草精品久久久久
黄色av网址在线观看
又黄又爽又湿又无遮挡的在线视频
精品在线免费观看视频
性久久久久久久久久久久久久
亚洲欧洲日韩二区aaaaa
亚洲一片二片
欧美日韩国产一区二区
国产一区二区三区黄色
999九九九久久久
www.国产免费观看3785
bettyblue
久久久久se
国产一级片播放
九九热在线视频观看
亚洲一区二区三区精品在线观看
亚洲视频七区
亚洲v欧洲一区二区三区
亚洲免费视频二区
久久在线精品视频
日本黄色高清视频网站
午夜a级片
伸进胸罩~嗯~好舒服~
亚洲第一成人av
精品久久久久久久久久中出
久久久精品一二三区
av一级在线观看
亚洲天堂一二三四区
欧美一区二区精品
久久天天操
av一区二区三区
久久久久久久久精
日韩一区二区三区在线观看
亚洲蜜桃在线
久久99国产精品久久99大师
刁三讲故事合集
日本一二区在线观看
久久综合狠狠综合久久狠狠色综合
久久91视频
大城小事
青青草原精品99久久精品66
精品久久久久久久人人人人传媒
国产精品久久久国产偷窥
国产日韩二区
丰满少妇被猛烈进入白浆
欧美日韩在线不卡
蜜桃69av
久久精品2
99久久99久久精品国产片果冰
刁三讲故事最新视频专场166集
成人免费av在线播放
久久九九集合九九国产精品
亚洲一区二区三区四区视频
av黄色免费观看
天堂色av
日本亚洲高清
久久天天综合桃花久久
九九免费
国产成人在线观看av
欧美一区二区三区四区视频
亚洲精品一区二区三区在线
亚洲第一区第二区
又黄又爽又无遮挡的视频
中文字幕av不卡
久久综合久久鬼
夜间av免费看精品
日本成人精品
蜜臀av免费在线观看
久久91视频
午夜一级片
国产又黄又爽免费视频
午夜激情视频在线观看
久久久久精彩视频
中文字幕av一区二区
国产精品性做久久久久久
日本三级日本三级韩国三级视
a级在线免费视频
中文字幕一区二区三区视频
女人扒下脱了内裤光着视频
成年人天堂
免费观看黄色
日韩免费三级电影
亚洲一区二区三区观看
国产精品第八页
国产精品欧美日韩
污污视频在线免费
99在线观看精品视频
国产精品wwww免费下载app
日本一区二区精品
成人区一区二区
少妇丰满极品嫩模白嫩
亚洲熟肉一区二区三区在线观看
国产五月天在线观看
久久精精品久久久久噜噜
99re视频在线免费观看
催眠术动漫
精品一区二区三区国产
www.国产免费观看3785
中文字幕九九
久久久久se
日韩美女一区
国产精品露脸高清86网站888
久久精品8
国产日b片
成人在线观看亚洲
国产亚洲一区二区三区在线观看
又黄又无遮挡
久久精品视频99
欧美精品在线观看
久久久久久国产精品免费无遮挡
精品欧美一区二区三区久久久
国产1区二区
国产精品久久久久9999高清
国产黄色免费观看
久久一本精品
在线观看国产一区二区三区
精品久久久91
国产成人在线观看av
国产欧美高清
亚洲一区在线看
日本精品在线免费观看
亚洲精品日本
99精品视频在线观看视频
91精品啪在线观看国产81旧版
直接看的av
日本三级日本三级韩国三级视
校花在校长室被调教h
国产成人av免费
国产无吗一区二区三区在线欢
亚洲精品欧美精品
国产成人高清视频
国产精品久久久久久久久久ktv
中文字幕一区二区在线免费观看
国产精品久久久久av电视剧
久久久久久久久影视
男儿当入樽粤语版全集
蜜桃av免费在线观看
亚洲综合av一区二区
天堂免费av
日韩三级电影在线观看
国产又黄又爽又色视频
久久久专区
国产成人精品在线观看
日韩亚洲欧美一区二区三区
让男生摸美女光屁屁无遮挡
久久久久综合视频
亚洲欧洲日本一区二区三区
我的黑帮大佬第2季免费经典电影
精品视频久久久久久
乱世家人
www.香蕉av
婬荡的寡妇播放
国产免费av一区二区
av女优在线看
亚洲日本视频在线观看
av在线播放一区二区
亚洲免费一二三区
久久爽久久爽久久免费观看
欧美在线观看一区
一区二区三区日本在线观看
午夜无码国产理论在线
中文字幕在线观看免费
av黄色成人
国产一区中文字幕
久久精品免费看国产免费软件
国内精品久久久
蜜桃一区二区三区在线观看
国产一级二级在线观看
亚洲一区二区三区自拍
亚洲成亚洲乱码一二三四区软件
亚洲美女一二三区
我和黑帮大佬的365日
99精品免费久久久久久日本
无遮挡肉动漫
久久久综合色
成年人视频在线看
国产精品区在线观看
国产91在线观看丝袜
国产精品不卡在线观看
国产精品伦一区二区三级视频
亚洲一区二区电影网
国产精品久久久久久久久久ktv
亚洲欧美国产高清
97色在线观看免费视频
欧美一区二区三区四区五区
日本福利在线观看
国产精品亚洲一区二区三区在线
色噜噜狠狠狠综合曰曰曰
国产一区二区三区黄色
国产成人av免费观看
美女揉胸动态图
视频一区二区免费
曰韩欧美精品
日韩精品三区
久久久久久久久影院
久久色精品
高清一区二区在线观看
97影院在线观看视频
高清一级黄色片
久久视频国产
www.av在线免费观看
国产精品18久久久
热re99久久精品国99热线看
久久精品无码一区二区日韩av
久久久久中精品中文字幕19
精品成人av
一区二区三区国产
久久精品视频网址
国产一区二区三区高清视频
亚洲日本二区
久久久精品视频在线观看
欧美久久一区
国产黄视频在线免费观看
亚洲色图av在线
一区二区三区亚洲精品国
久久久久久久久久久97
久久国产极品
国产精品爽爽久久久久久
久久久久久久久网站
高清一区二区
国产又黄又爽又刺激的视频
久久做久久
久久久精品视频在线观看
日韩区一区二区三
亚洲高清无吗
1000国产精品成人观看视频二